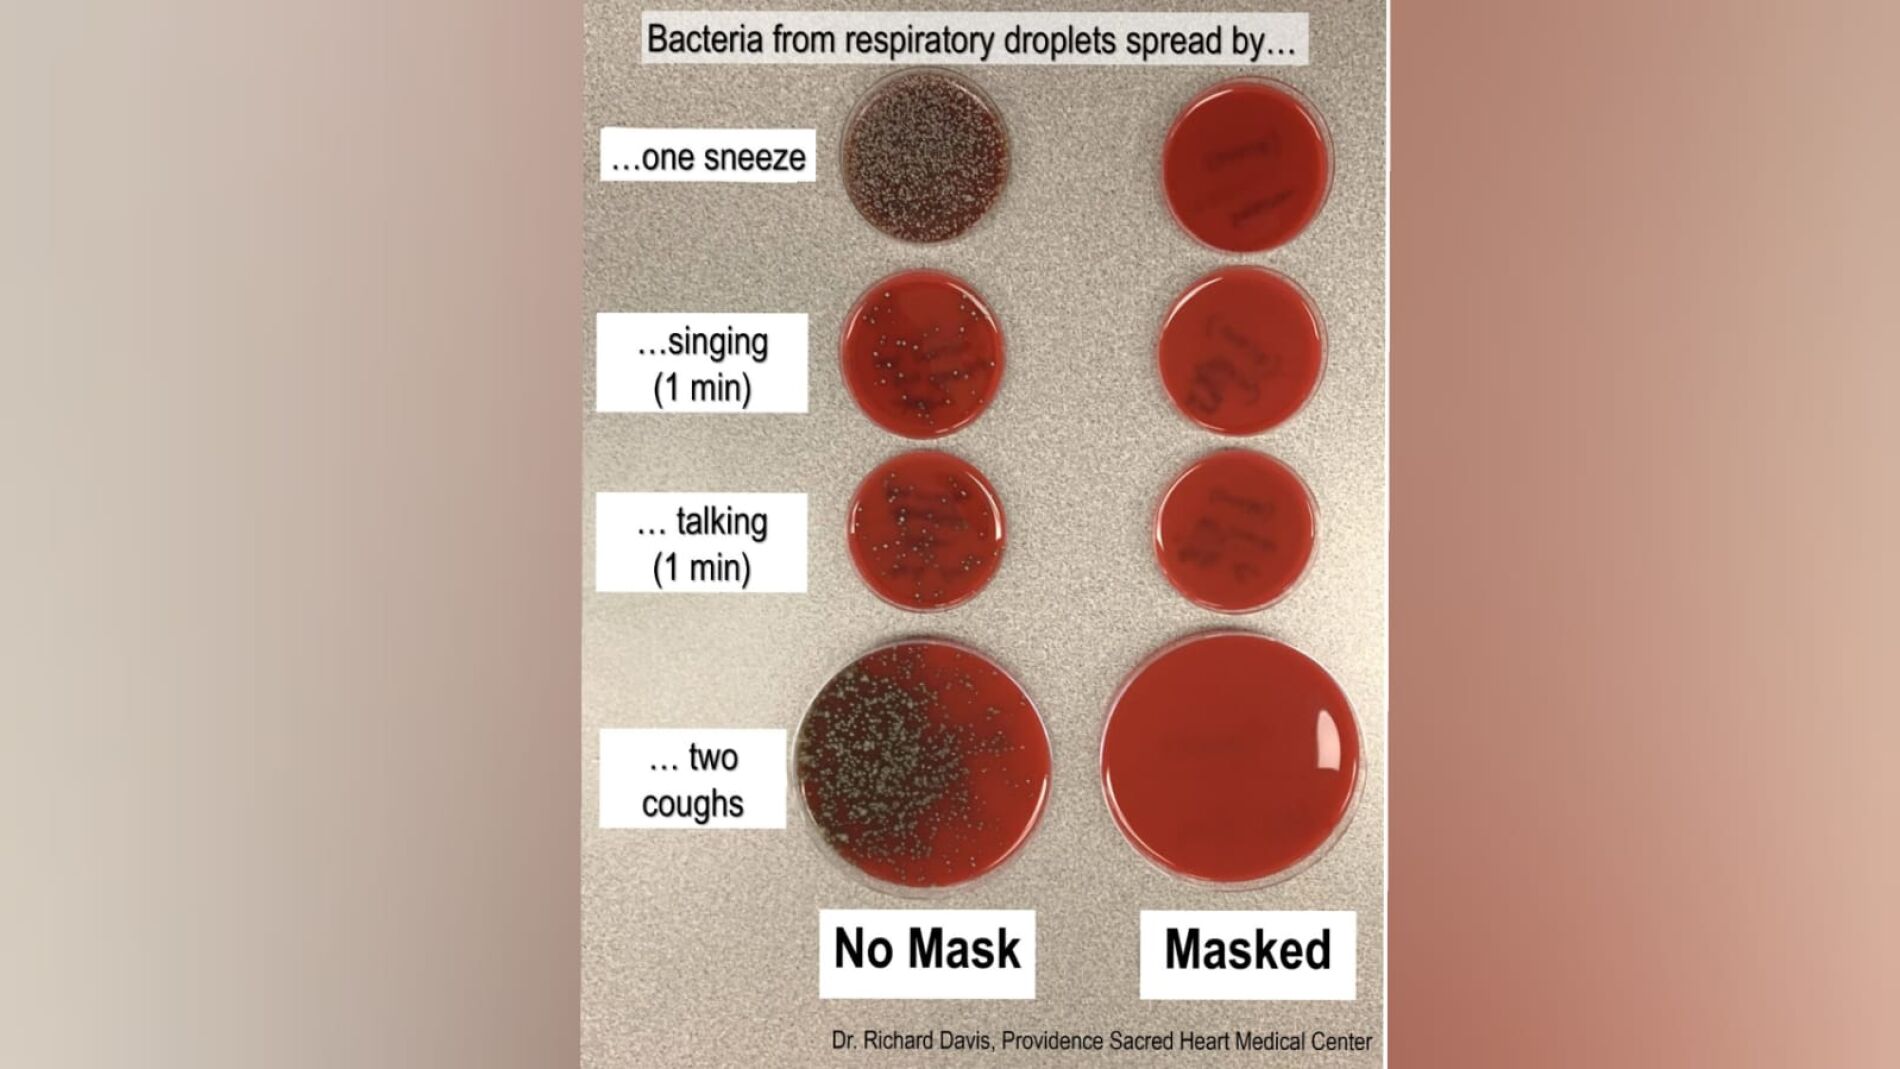
Estudio sobre los g&eacute;rmenes que expulsamos al toser

Coronavirus
Un investigador muestra en un experimento lo que expulsa una persona que no usa mascarilla
Un científico ha hecho público los resultados de su experimento para concienciar a la población del uso de mascarillas para prevenir y evitar contagios por coronavirus.
Publicidad
Las autoridades sanitarias han establecido el uso de mascarillascomo medida obligatoria en algunos países del mundo, con el objetivo de prevenir y evitar posibles contagios por coronavirus en el camino hacia la nueva normalidad.
Rich Davis, director del Laboratorio de Microbiología Clínica del Sagrado Corazón de Providence (EEUU), ha realizado un experimento que muestra lo que expulsa una persona que lleva mascarilla y sin ella. Los resultados los ha hecho públicos en sus redes sociales para concienciar a la ciudadanía de la importancia de respetar las medidas higiénico-sanitarias, especialmente de la eficacia del uso de mascarillas. “Nos lavamos las manos después de usar el baño y nos limpiamos la nariz con pañuelos de papel. Las máscaras y las pantallas faciales deben ser sólo otro acto de higiene normalizado”, sostenía a través de su cuenta de Twitter.
En la prueba, el investigador primero estornudó, cantó, habló y tosió “hacia una placa de cultivo de agar con y sin máscara”. En la fotografía que incluyó en la publicación, se aprecia cómo las colonias de bacterias muestran dónde cayeron las gotas. Después, colocó las placas de cultivo de bacterias abiertas a 2, 4 y 6 pies de distancia, sobre las que tosió fuerte durante 15 segundos, igualmente con y sin mascarilla.
Aunque Davis señala que es “consciente de que esta simple demostración no es la forma en que se cultivan los virus o el modelo de propagación del coronavirus”, explica que las gotas aterrizaron en su mayoría a los 6 pies de distancia, pero por el contrario, el uso de máscara bloqueó casi todas ellas.
“Las colonias de bacterias normales de mi boca/garganta muestran la propagación de grandes gotas respiratorias, como las que creemos que se propagan principalmente por el coronavirus, y cómo una máscara ¡puede bloquearlas!”, concluyó el investigador.
Más Noticias
-
La preocupante advertencia de los expertos: "La Tierra no puede sostener a la futura población humana, ni siquiera a la actual"
-
Logran frenar el síndrome de Tourette grave de un joven mediante electrodos en el cerebro: "Me ha cambiado la vida"
-
El lince ibérico blanco de Jaén está recuperando su color natural

Publicidad









